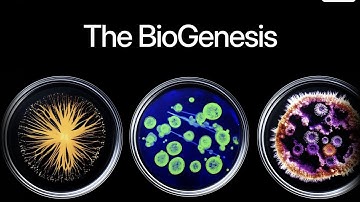
An NFT That Evolves and Earns Rewards? Discover Haust Network’s Innovation‼️😍

⬇ DOWNLOAD NOW
Kalau muncul iklan pop-up, tutup lalu klik tombol kembali
Download lagu Haust.Network at DeFi.World | Reshaping DeFi with Innovation and Restaking secara gratis hanya untuk keperluan promosi. Dukung artis favorit kamu dengan membeli musik original di iTunes atau platform resmi lainnya.
 Haust.Network at Staking Summit 2024 | Insights on Restaking and DeFi Evolution
Haust.Network at Staking Summit 2024 | Insights on Restaking and DeFi Evolution
An NFT That Evolves and Earns Rewards? Discover Haust Network’s Innovation‼️😍
An NFT That Evolves and Earns Rewards? Discover Haust Network’s Innovation‼️😍
 Haust Network Takes Center Stage at Crypto Expo Dubai | May 2024 Highlights
Haust Network Takes Center Stage at Crypto Expo Dubai | May 2024 Highlights
 Haust.Network at Token 2049 | Highlights & DeFi Innovation Recap
Haust.Network at Token 2049 | Highlights & DeFi Innovation Recap
 Haust Network DeFi Made Easy
Haust Network DeFi Made Easy
 Haust.Network at Token 2049 | Simple and Secure Multichain Yield
Haust.Network at Token 2049 | Simple and Secure Multichain Yield
 Haust.Network at Aggregation Summit | Conversations about the future of AggLayer.
Haust.Network at Aggregation Summit | Conversations about the future of AggLayer.
 HAUST Network: The L2 Blockchain Revolution with Native Yield 🚀
HAUST Network: The L2 Blockchain Revolution with Native Yield 🚀